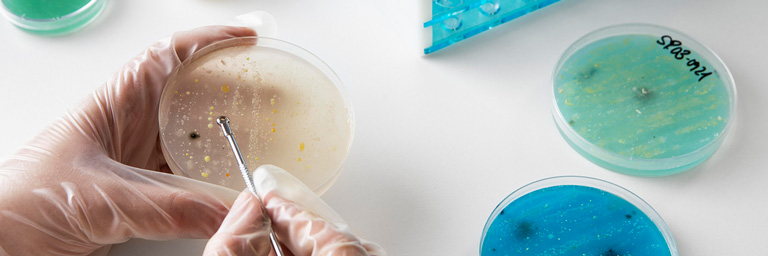

Traitements des infections urinaires de l’enfant
Mise à jour 2024
Mise en ligne Septembre 22, 2024
Mise à jour 2024
Les infections urinaires de l’enfant
En cas de fièvre, on retrouve une infection urinaire chez 7,5 % des filles de moins de 3 mois, 20 % des garçons non circoncis, et 2,4 % des garçons circoncis.
Au-delà de 1 an, l’infection urinaire touche plus souvent les filles que les garçons, avec un pic de fréquence vers 2 à 3 ans.
Une bandelette urinaire positive pour les leucocytes ou les nitrites doit précéder la réalisation d’un examen cytobactériologique des urines et toute antibiothérapie.

L’association d’une fièvre élevée à 39 à 40 C, de frissons, de sueurs, d’une altération de l’état général, de douleurs abdominales ou lombaires est évocatrice de pyélonéphrite aiguë.
Lorsqu’il y a une infection urinaire basse ou une cystite, les symptômes cliniques chez l’enfant se limitent à des signes vésicaux comme une pollakiurie, des brûlures mictionnelles, des douleurs hypogastriques et parfois une hématurie.
Confirmation de Diagnostic :
On commence par une chimie des urines par bandelettes réactives, recherchant les nitrites et la leucocyturie. Quand ces deux tests sont négatifs, la valeur prédictive négative est proche de 98 %, tandis que la valeur prédictive positive est plus basse, à 75 %.
Si la bandelette est positive, il est essentiel de procéder systématiquement à un examen cytobactériologique des urines (ECBU) avec antibiogramme pour confirmer une infection urinaire.
Rechercher une pathologie, une information…..
Comment on traite les infections urinaires ?
Dès que le diagnostic est confirmé, le traitement antibiotique doit être initié immédiatement, avant de connaître le germe et l’antibiogramme.
La sélection initiale de l’antibiothérapie est basée sur la connaissance du profil de résistance des germes urinaires les plus fréquemment observés localement.
Le traitement est guidé par l’examen bactériologique direct des urines et le résultat de l’antibiogramme.

Quel que soit le traitement initial, et a fortiori s’il s’agit d’un traitement oral, il faut récupérer le plus rapidement possible le résultat de l’antibiogramme afin d’adapter le traitement au plus tard dans les 36–48 h en cas de souche résistante.